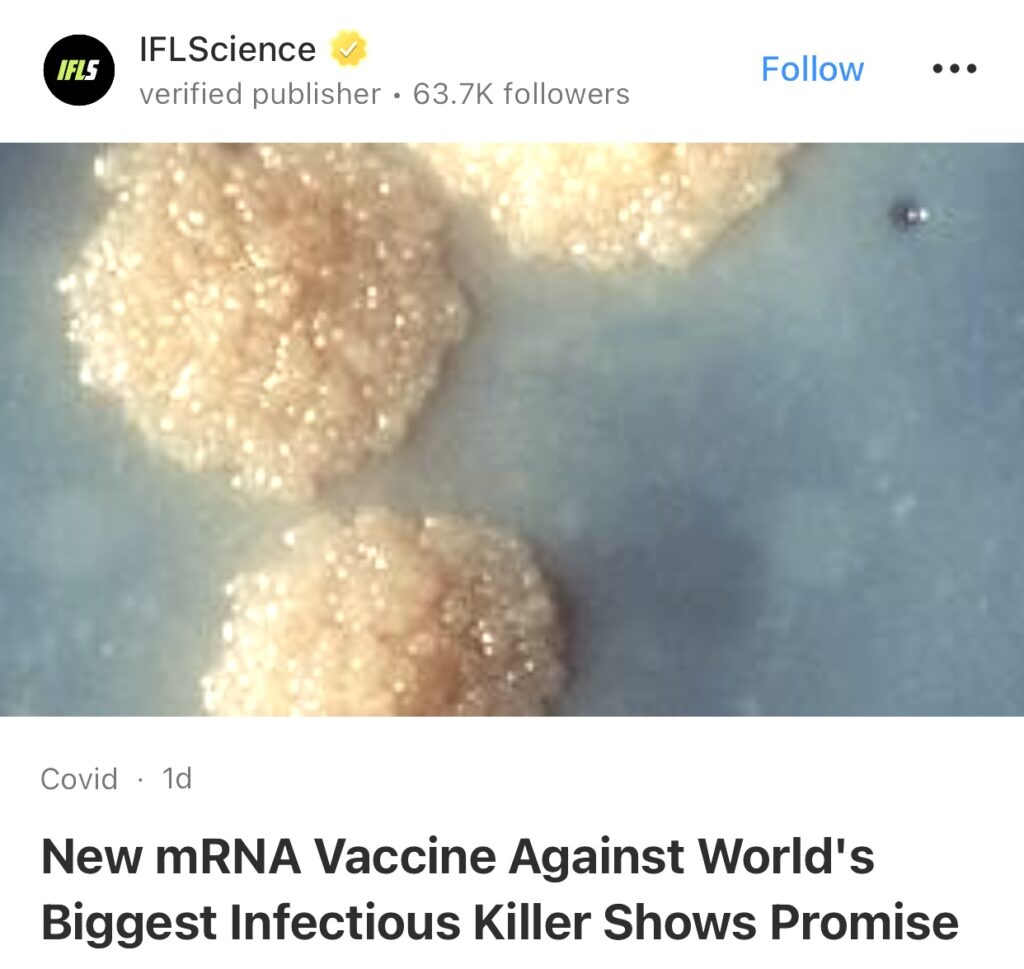

1。据iHeartRadio报道,中国发现可能引发另一场大流行的新型冠状病毒。中国发现了一种名为 HKU5-CoV-2 的新型冠状病毒,引发了人们对其可能引发大流行的担忧。该病毒是由石正丽领导的一个研究小组发现的,石正丽是一名病毒学家。HKU5-CoV-2 是 HKU5 冠状病毒的一个新谱系,最初在香港的日本蝙蝠中发现。

2。据IFLScience报道,针对世界上最大传染病杀手的新型 mRNA 疫苗显示出希望。一种针对结核病 (TB) 的新型 mRNA 疫苗在临床前试验中显示出良好的结果。目前只有一种获得批准的结核病疫苗——结核病最近超过了 COVID-19,再次成为地球上最致命的传染病——这些发现是在对抗人类古老敌人的斗争中向前迈出的一大步。
3。据Oilprice报道,美国主要媒体称,美国情报机构得出的结论是,以色列在未来几个月内袭击伊朗核计划的可能性很高,但以色列能否独自摧毁其宿敌的核设施尚无定论。

4。据New York Post报道,特朗普顾问敦促泽连斯基重返谈判桌,美国向乌克兰提供“改进的”稀土矿产协议。

5。据The Independent报道,中国科学家推出突破性疗法,可挽救核辐射中的生命。一项新的研究表明,一种突破性的新疗法使小鼠能够在急性辐射下生存,这可能会导致更安全的癌症治疗并在核战争中拯救生命。

6。据Reuters报道,消息人士称,作为乌克兰战争解决方案的一部分,俄罗斯可能会接受被冻结的3000亿美元资产。

7。据The Mirror US报道,法国总统马克龙表示,他计划告知美国总统特朗普,面对俄罗斯领导人普京,尤其是在美国主导的解决乌克兰近三年冲突的谈判期间,不要“软弱”,这符合美国和欧洲的共同利益。据白宫称,马克龙定于周一前往华盛顿与特朗普会面。

8。据New York Post报道,美国官员警告哈马斯如果在希里·比巴斯的尸体未归还后,还不释放所有人质,将面临“彻底歼灭”。

9。据Business Insider 报道,Nvidia首席执行官黄仁勋直接谈到了DeepSeek股票的抛售,称投资者错了。

10。据Straight Arrow News报道,法国创造核聚变新纪录,超越中国。据法国替代能源和原子能委员会称,法国的核聚变反应堆打破了中国此前保持的记录。法国的反应堆保持稳定的等离子体循环超过22分钟,超过了中国18分钟的记录。

11。据People 报道,6 岁先天失明男孩在“改变生活”的基因治疗后视力部分恢复。

12。据Space.com报道,美国太空军首次展示在轨秘密 X-37B 太空飞机照片。这张周四(2 月 20 日)发布的照片是由 X-37B 上的相机拍摄的,当时这架神秘的太空飞机在非洲大陆上空高空运行。该飞行器已在轨道上运行一年多了,于 2023 年 12 月 28 日搭载SpaceX 猎鹰重型火箭执行第七次任务。

13。据Interesting Engineering报道,中国在全球量子计算霸主地位的争夺中迈出了重要一步。北京大学研究人员在光学芯片上成功演示了大规模量子纠缠,标志着量子技术的一个重要里程碑。

14。据Straight Arrow News 报道,乌克兰加强了对俄罗斯能源设施的无人机袭击,袭击了多个炼油厂和一条重要的石油管道,迫使其关闭并扰乱了原油运输。这些袭击旨在削弱莫斯科的战争能力并向俄罗斯施加经济压力。

15。据上海路透社报道,据中国官方媒体报道,华为创始人在中国国家主席与私营部门企业家举行的会议上告诉习近平,中国对缺乏国产芯片或操作系统的担忧已经缓解。

以下为华人服务广告区:






如果大家喜欢“简报”,希望登陆网站americannewsdigest24.com, 点击小铃铛订阅,每月仅$2美元。有你们的支持我会把“简报”办得更好。谢谢!
顾震帝 2025年,02月23日。

Hello Neat post Theres an issue together with your site in internet explorer would check this IE still is the marketplace chief and a large element of other folks will leave out your magnificent writing due to this problem
BusinessIraq.com maintains thorough coverage of Iraq’s rapidly evolving financial services sector. Our platform reports on banking reforms, fintech innovations, and insurance market developments, providing essential information for financial professionals and investors. Special focus is given to digital banking initiatives, Islamic finance developments, and monetary policy changes that impact Iraq’s business environment. Through expert analysis and exclusive interviews, we help readers navigate the complexities of Iraq’s financial landscape.
For comprehensive coverage of the telecommunications sector in Iraq, Iraq Business News is an invaluable resource. The site provides updates on regulations, market entrants, and technological advancements that shape this fast-paced industry.
The Iraqi economy’s transformation receives detailed attention on BusinessIraq.com, with expert analysis of GDP growth, trade balances, and foreign investment flows. Drawing from various economic indicators and market research, we track economic reforms, privatization initiatives, and monetary policy developments. Our coverage extends to international trade agreements, economic partnerships, and cross-border business opportunities that shape Iraq’s economic future.
Thank you for the auspicious writeup It in fact was a amusement account it Look advanced to far added agreeable from you However how can we communicate
Your blog is a testament to your expertise and dedication to your craft. I’m constantly impressed by the depth of your knowledge and the clarity of your explanations. Keep up the amazing work!
Your blog has quickly become one of my favorites. Your writing is both insightful and thought-provoking, and I always come away from your posts feeling inspired. Keep up the phenomenal work!
I just could not leave your web site before suggesting that I really enjoyed the standard information a person supply to your visitors Is gonna be again steadily in order to check up on new posts
Thank you I have just been searching for information approximately this topic for a while and yours is the best I have found out so far However what in regards to the bottom line Are you certain concerning the supply